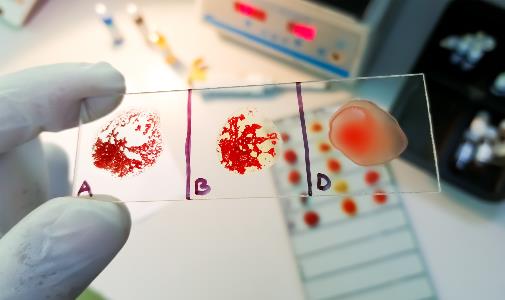
course-image-6685.jpg

Rare blood case study
About this case study
This case study leads you from patient presentation and initial laboratory findings to consideration of challenges presented both clinically and in the laboratory. There is a quiz at the end of the module to assess your learning from the case study.
Please provide your feedback via the 'Feedback survey' link after completing the case study and passing the quiz.
Learning outcomes
At the completion of this case study, you should be able to:
- Identify the key antigens of the YT blood group system, including Yta and Ytb, and their clinical relevance.
- Explain the significance of anti-Yta, understand that its strength may change over time, and outline the risk assessment for transfusing Yt(a+) units in the presence of anti-Yta.
- Assess the impact of additional alloantibodies (e.g. anti-K, anti-Jka) on transfusion planning and the importance of extended antigen matching to prevent further alloimmunization e.g. due to Rh, K, Jka, Jkb, Fya, Fyb, Ss antibodies.
- Discuss clinical decision-making and risk management including recommendations for supportive therapy in challenging transfusion cases when perfectly matched units are unavailable.
-
Investigate rare donor search strategies available to your laboratory, clinical or blood supply environment.
-
Describe the role of appropriate clinical monitoring in the case of transfusion of red cells carrying incompatible antigens.























